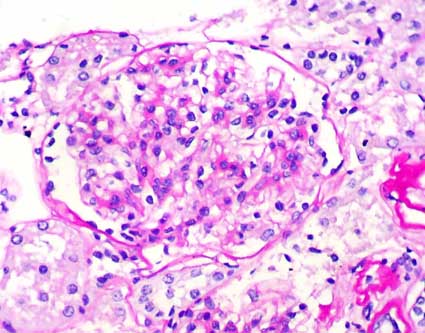

CASO
24 (Febrero 2008)
Datos clínicos
Niña de 8 años de edad
con un año de evolución de síndrome nefrótico
que ha presentado episodios de mejoría y de exacerbación
intermitentes, con aparente "respuesta parcial" a esteroides.
No ha recibido otros inmunosupresores. Ha presentado, además, varios
episodios de hematuria macroscópica que dura varios días.
En algunos de los citoquímicos de orina realizados cuando no presentaba
hematuria macro se ha detectado hematuria microscópica: entre 6
y 40 eritrocitos por campo de gran aumento. Proteinuria máxima
5,5 g/24 horas, aproximadamente 220 mg/m2/h. Leve hipercolesterolemia.
Hipoalbuminemia.
En la revisión por sistemas relata
dolor abdominal leve, difuso, de varios días de evolución.
No hay síntomas gastrointestinales, no relata fiebre ni episodios
catarrales en el último mes. No relata lesiones de piel.
Al exámen físico presenta
edema generalizado. No hay hipertensión ni alteraciones en piel
o mucosas. No hay visceromegalias ni adenomegalias. No se detectan otras
alteraciones.
¿Cuál es su diagnóstico
clínico?
Con el diagnóstico de síndrome
nefrótico y hematuria macroscópica intermitente se toma
biopsia renal.
Observe las imágenes.

Figura 1.
En la mayoría de glomérulos hay proliferación mesangial
leve o moderada (H&E, X400).

Figura 2.
Mayor grado de proliferación celular mesangial que en la imagen
anterior (H&E, X400).

Figura 3.
En algunos glomérulos hay además hipertrofia de podocitos
(Tricrómico de Masson, X400).
Figura 4.
PAS, X400.

Figura 5.
Plata-metenamina, X400.

Figura 6.
Inmunofluorescencia directa para IgA. En el glomérulo de la izquierda
predomina la inmunotinción mesangial, pero en el de la derecha
hay también múltiples depósitos granulares parietales
(X400).

Figura 7.
Inmunofluorescencia directa para IgG (izquierda): depósitos mesangiales
y parietales. La inmunofluorescencia para IgM (derecha) muestra escasos
depósitos parietales y mesangiales: trazas. Ambas imágenes,
X400.

Figura 8.
Inmunofluorescencia directa para C3 (izquierda): depósitos mesangiales
y parietales escásos y débiles. Inmunofluorescencia para
C1q (derecha): trazas focales y segmentarias. Ambas imágenes, X400.

Figura 9.
Inmunofluorescencia directa para cadenas ligeras Kappa (izquierda): depósitos
mesangiales y parietales granulares difusos. Inmunofluorescencia para
cadenas ligeras Lambda (derecha): también hay depósitos
granulares parietales y mesangiales difusos.
¿Cuál es su diagnóstico?
Ver
diagnóstico y discusión
[Arriba]
|